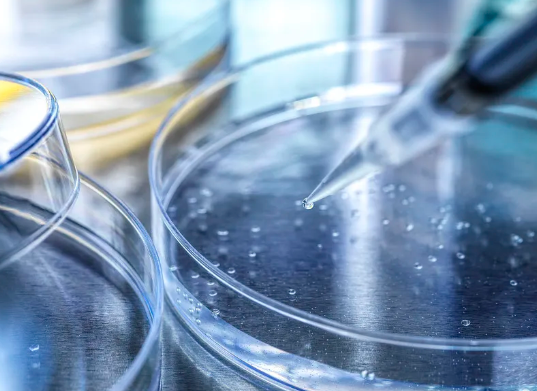
image.png

nk細胞怎麽提取,内附提取步驟及适應症
2024-10-17 11:27:10 來源: 小編 咨詢醫生
自然殺傷細胞(Natural Killer,NK)細胞是人體免疫系統中的一種重要細胞,負責識别并消滅感染細胞和腫瘤細胞。近年來,NK細胞成爲細胞治療領域中備受關注的研究熱點,其提取及應用日益廣泛。那麽,NK細胞怎麽提取呢?本文将爲你詳細解讀NK細胞的提取步驟及其适應症。
一、NK細胞提取步驟概述
NK細胞提取是一個精确的生物技術過程,通常包括以下幾個步驟:
1.采血:
從供者或病人體内抽取全血,這是提取NK細胞的第一步。
2.分離單個血細胞:
使用密度梯度離心法,比如福柯林法(Ficoll method)或其他分隔介質,可獲得單個血細胞(PBMCs)。此過程将血漿、紅細胞等與單核細胞分離。
3.NK細胞富集:
采用免疫磁珠技術或流式細胞分選法(FACS)對PBMCs進行分選,富集NK細胞。免疫磁珠法是通過抗體結合NK細胞的特異性表面标志物,如CD56和CD16抗體,與磁珠相結合,通過磁力分離NK細胞。流式細胞分選是通過對細胞進行标記後,利用激光和電學性質對細胞進行分類和回收。
4.NK細胞純化與培養:
獲得的NK細胞通常需要進一步純化和在特定條件下培養,通過添加細胞因子和生長因子等方法,使NK細胞擴增并達到治療所需的細胞數量和質量。
5.質量控制:
通過相關細胞功能檢測和安全性評估(如活性、純度、細胞存活率及是否存在污染),确保提取的NK細胞适用于臨床治療。
二、NK細胞的适應症
NK細胞療法在多種适應症中展現了潛力,主要包括:
-惡性腫瘤:
NK細胞能夠識别并殺死多種類型的癌細胞,例如白血病、淋巴瘤、胃癌、肺癌等。
-病毒感染:
NK細胞在抵抗某些病毒感染中扮演重要角色,比如HIV、HBV以及流感病毒。
-免疫調節:
通過NK細胞的調節作用,可以改善一些免疫相關疾病的症狀,如自身免疫疾病。
-細胞移植(如造血幹細胞移植)中的應用,可提高移植成功率,減少排斥反應。
結論:
NK細胞提取的步驟精細而複雜,且必須在專業的實驗室條件下進行,以确保所提取的NK細胞安全、有效。随着細胞治療技術的發展,NK細胞治療的适應症範圍正在拓寬,其中惡性腫瘤的治療尤爲積極研究。不過,NK細胞治療尚在臨床試驗階段,未來的研究将進一步驗證其廣泛的療效與适應症。與此同時,科學家們也在不斷探索NK細胞提取和培養的最佳條件,助推細胞治療領域前進。
本文出自:https://www.hnxbk.com/news/1624.html
- 2024-10-14胎盤幹細胞
- 2024-10-16全能幹細胞有哪些,幹細胞分幾種都有哪些功能
- 2024-10-12幹細胞培養全過程視頻哪裏有?怎樣正确操作幹細胞培養?
- 2024-10-31幹細胞護膚過程中需要注意哪些事項?
- 2024-11-06人體幹細胞來源之謎與功效揭秘:來源是哪?如何發揮作用?
- 2024-09-27貝拉國際細胞醫療怎麽樣
- 2024-08-01做幹細胞價格表,做幹細胞移植手術有風險嗎
- 2024-08-12間充質幹細胞抗衰老的效果怎麽樣
- 2024-08-14幹細胞抗衰老持續效果怎麽樣
- 2024-10-10幹細胞研究合作上有哪些新進展?近期有何突破性成果?
- 2024-10-02幹細胞返老還童研究進展怎樣,有哪些突破性發現
- 2024-09-05日本幹細胞治療帕金森病最新臨床進展
- 2024-10-11上海幹細胞醫療中心有幾家?如何選擇專業機構?
- 2024-08-27造血幹細胞捐獻危害,對身體有影響
- 2024-09-11醫院幹細胞存儲費用多少,2024最新細胞儲存方案
- 2024-07-22幹細胞移植費用,幹細胞移植成功率高嗎
- 2024-07-31自體脂肪幹細胞效果,自體脂肪幹細胞的作用和功效
- 2024-10-11幹細胞結合中藥治療腫瘤靠譜嗎?哪些機構值得信賴?
